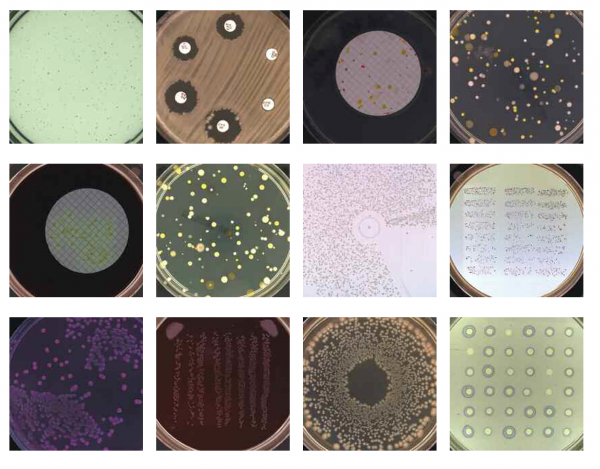
synbiosis, synoptics, colony counter, koloni sayım, koloni analiz, protocol 3, protocol 3 plus, protocol 3 HDE, protocol 3 HDE plus, zone measuring, koloni, gen plaza, chromosome, chromoscan

KOLONİ SAYIM VE OTOMATİK ANALİZ SİSTEMLERİ
Synbiosis, ProtoCOL 3, ChromaZona ve ProcScan sistemleriyle Antibiyotik Duyarlılık Testi (AST) ve Tek Yönlü Radyal İmmünodiffüzyon (SRD) testlerinde doğru ve tekrarlanabilir bölge ölçümü için (Zone measuring) son teknoloji çözümler sunmaktadır.
Otomatik Mikrobiyal Analiz için Çok Yönlü Hassasiyet
Synbiosis ProtoCOL 3, hızlı, doğru ve izlenebilir mikrobiyolojik sonuçlar sunmak üzere tasarlanmış yüksek performanslı otomatik koloni sayımı ve inhibisyon bölgesi ölçüm sistemidir. Gelişmiş görüntüleme teknolojisini akıllı yazılımla birleştiren ProtoCOL 3, klinik, farmasötik, çevresel ve gıda mikrobiyolojisi laboratuvarları için koloni sayımını ve inhibisyon bölgesi ölçümünü kolaylaştırır.
Yüksek çözünürlüklü kamera ve üç renkli LED aydınlatma ile donatılmış ProtoCOL 3, tüm agar türlerinde kolonilerin ve inhibisyon bölgelerinin doğru tespiti için keskin, yüksek kontrastlı görüntüler yakalar. Sistemin rafine optikleri ve gelişmiş analiz algoritmaları, küçük veya soluk koloniler için bile tekrarlanabilir sonuçlar sağlar ve bu da onu çok çeşitli mikrobiyolojik testler için ideal hale getirir.
Kapasite
ProtoCOL 3, tek bir düğmeye dokunarak kolonileri otomatik olarak sayar veya bölgeleri ölçer ve çok düşük çaplara kadar plakaları olağanüstü hız ve güvenilirlikle işler. Modüler tasarımı, koloni sayımı, bölge ölçümü, spiral plaka analizi, eAST ve Ames testleri de dahil olmak üzere birden fazla yazılım uygulamasını destekleyerek, otomatik plaka okuma için esnek, hepsi bir arada bir platform sunar.
Uyumluluk
Düzenlemeye tabi laboratuvarlarda kullanım için tasarlanan ProtoCOL 3, güvenli denetim izleri, kullanıcı erişim kontrolü ve veri bütünlüğü koruma önlemleriyle 21 CFR Bölüm 11’e tamamen uyumludur. Sonuçlar Excel, PDF veya LIMS’e sorunsuz bir şekilde aktarılabilir, böylece tam izlenebilirlik ve GLP ve GMP gerekliliklerine uyumluluk sağlanır.
Uygulama Alanları
- Ames testing
-
Antibiotic susceptibility test – AST
-
Bioburden membrane filtration
-
Environmental monitoring – Settle plates
-
Microbial limits test – membrane filtration
-
Microbial limits testing – pour plate
-
Multi-sector plates
-
OPKA – opsonophagocytic killing assay
-
Preservative efficacy testing
-
Serum bactericidal assay – SBA
-
Spiral plates
-
Single radial immunodiffusion – SRD
ve diğer uygulamalar..
Türkçe
English



